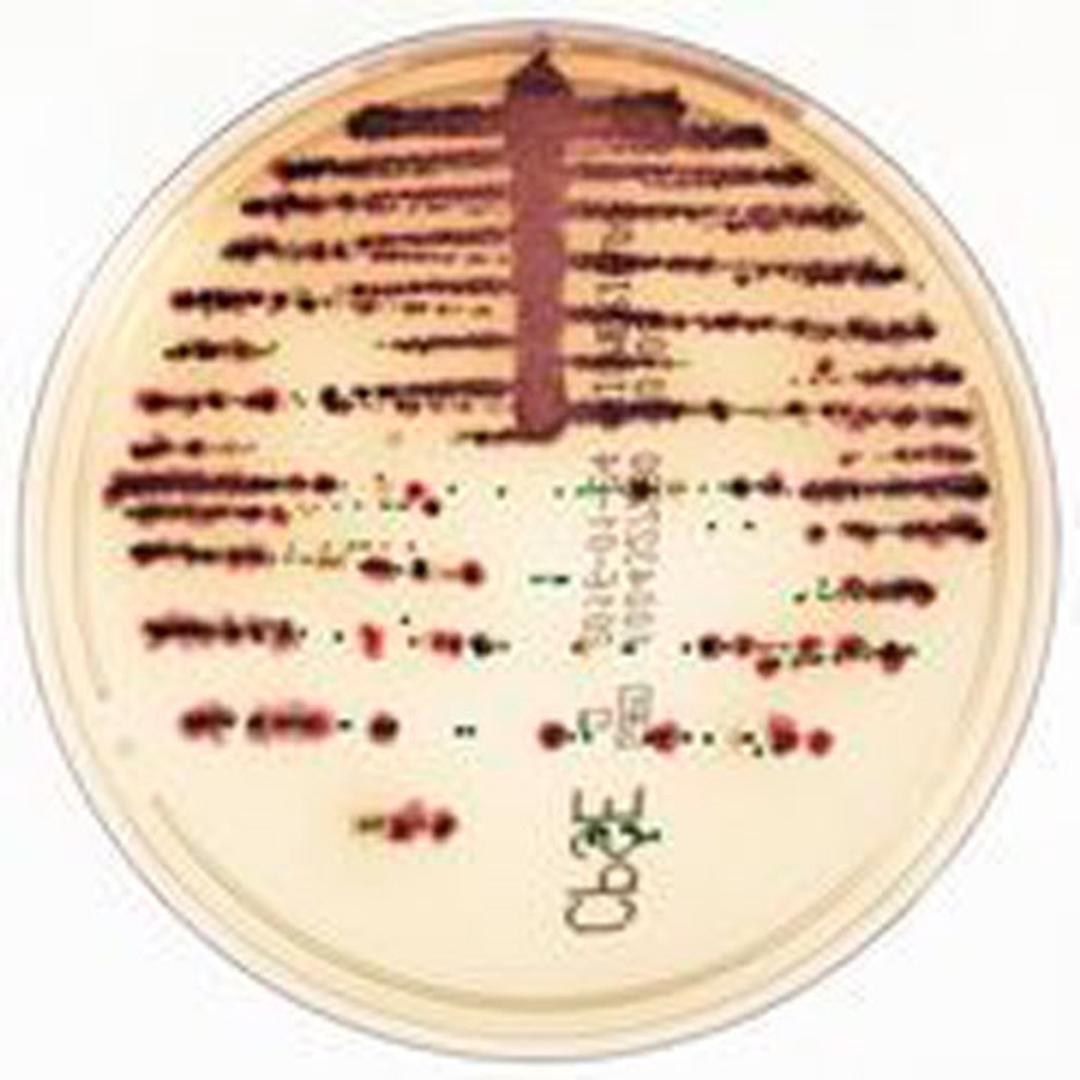

Products & ReviewLife Sciences
CHROMID®
Chromogenic media for organism isolation and identification.

The supplier does not provide quotations for this product through SelectScience. You can search for similar products in our Product Directory.
CHROMID provides clear, easy-to-read media that can be used by trained staff to aid in infection prevention efforts to control the spread of resistance in an institution. bioMérieux is a partner you can work with to enhance your antimicrobial stewardship efforts—providing faster, more accurate, and actionable results.